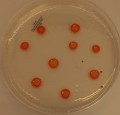

CECT 5871
ARCHAEA
Type strain
This strain has important remarks. Please read the strain data sheet carefully and completely.
| Name | Haloferax lucentense Gutierrez et al. 2004 | ||||
| Strain designation | Aa 2.2 | ||||
| Other collections | CCM 7023; CIP 107410; DSM 14919; JCM 9276; NCIMB 13854 | ||||
| Access in situ (sampling data) | Source: Saline water Country of access: Spain Locality, State of access: Alicante Date of access: Before 01-01-1986 | ||||
| Isolation data | Isolated by: Rodríguez-Valera, F. Date of isolation: 01-01-1986 | ||||
| History | CECT, 2002 < A. Ventosa, Univ. Sevilla, Spain < M. Dyall-Smith, Univ. Melbourne, Australia < F. Rodríguez-Valera, Univ. Alicante, Spain | ||||
| Growth conditions | Culture media: 366 Growth temperature (in °C): 37 Incubation time: 15d Atmospheric needs: aerobic Growth remarks: Use a shaker incubator at 100 rpm Cultivation conditions for CECT strains | ||||
| Restrictions | Risk group: 1 Restrictions on ABS imposed by the country of origin may apply CECT MTA | ||||
| Genetic data | G+C mol%: 64.5 16S rRNA sequence: AB081732 Complete genome sequence: GCA_000336795.1 | ||||
| Delivery |
| ||||
| La CECT sigue estándares de calidad para garantizar la viabilidad, pureza y autenticidad de las cepas que conserva. La información mostrada en esta ficha procede de diversas fuentes. Algunas de las propiedades no han sido necesariamente contrastadas por la CECT | |||||